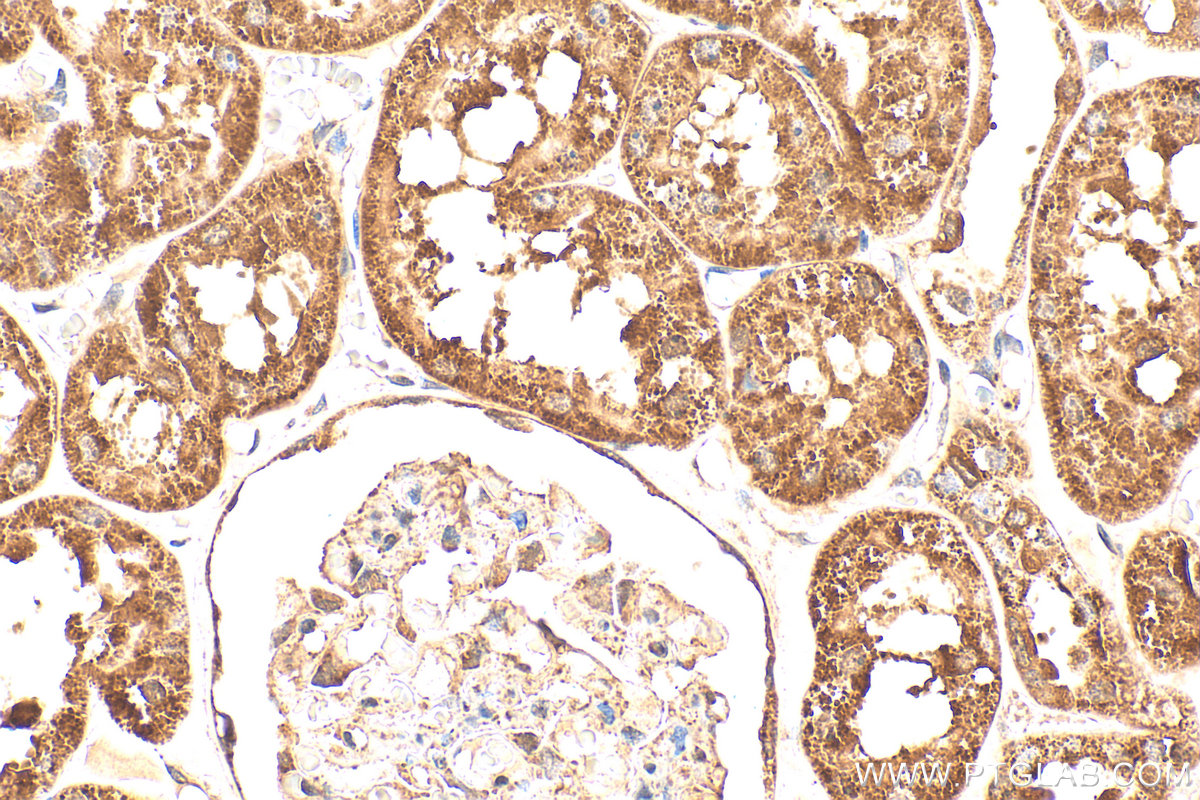
Immunohistochemistry (IHC) staining of human kidney tissue using Gamma Cystathionase Polyclonal antibody (12217-1-AP)

Tested Applications
| Positive WB detected in | HEK-293 cells, HeLa cells, HepG2 cells, mouse heart tissue, mouse kidney tissue, rat heart tissue, MDCK cells, pig kidney tissue, pig liver tissue, mouse liver tissue, rat liver tissue, rat kidney tissue |
| Positive IP detected in | mouse liver tissue |
| Positive IHC detected in | human liver cancer tissue, human breast cancer tissue, human kidney tissue Note: suggested antigen retrieval with TE buffer pH 9.0; (*) Alternatively, antigen retrieval may be performed with citrate buffer pH 6.0 |
| Positive IF-P detected in | human liver cancer tissue |
| Positive IF/ICC detected in | HepG2 cells |
| Positive FC (Intra) detected in | MCF-7 cells |
Recommended dilution
| Application | Dilution |
|---|---|
| Western Blot (WB) | WB : 1:5000-1:20000 |
| Immunoprecipitation (IP) | IP : 0.5-4.0 ug for 1.0-3.0 mg of total protein lysate |
| Immunohistochemistry (IHC) | IHC : 1:100-1:500 |
| Immunofluorescence (IF)-P | IF-P : 1:200-1:800 |
| Immunofluorescence (IF)/ICC | IF/ICC : 1:200-1:800 |
| Flow Cytometry (FC) (INTRA) | FC (INTRA) : 0.80 ug per 10^6 cells in a 100 µl suspension |
| It is recommended that this reagent should be titrated in each testing system to obtain optimal results. | |
| Sample-dependent, Check data in validation data gallery. | |
Published Applications
| KD/KO | See 25 publications below |
| WB | See 206 publications below |
| IHC | See 37 publications below |
| IF | See 17 publications below |
| IP | See 3 publications below |
| CoIP | See 2 publications below |
Product Information
12217-1-AP targets Gamma Cystathionase in WB, IHC, IF/ICC, IF-P, FC (Intra), IP, CoIP, ELISA applications and shows reactivity with human, mouse, rat, pig, canine samples.
| Tested Reactivity | human, mouse, rat, pig, canine |
| Cited Reactivity | human, mouse, rat, pig, rabbit, canine |
| Host / Isotype | Rabbit / IgG |
| Class | Polyclonal |
| Type | Antibody |
| Immunogen |
CatNo: Ag2872 Product name: Recombinant human CSE protein Source: e coli.-derived, PGEX-4T Tag: GST Domain: 74-406 aa of BC015807 Sequence: AVAALDGAKYCLAFASGLAATVTITHLLKAGDQIICMDDVYGGTNRYFRQVASEFGLKISFVDCSKIKLLEAAITPETKLVWIETPTNPTQKVIDIEGCAHIVHKHGDIILVVDNTFMSPYFQRPLALGADISMYSATKYMNGHSDVVMGLVSVNCESLHNRLRFLQNSLGAVPSPIDCYLCNRGLKTLHVRMEKHFKNGMAVAQFLESNPWVEKVIYPGLPSHPQHELVKRQCTGCTGMVTFYIKGTLQHAEIFLKNLKLFTLAESLGGFESLAELPAIMTHASVLKNDRDVLGISDTLIRLSVGLEDEEDLLEDLDQALKAAHPPSGSHS Predict reactive species |
| Full Name | cystathionase (cystathionine gamma-lyase) |
| Calculated Molecular Weight | 405 aa, 45 kDa |
| Observed Molecular Weight | 40-45 kDa |
| GenBank Accession Number | BC015807 |
| Gene Symbol | Gamma Cystathionase |
| Gene ID (NCBI) | 1491 |
| RRID | AB_2087497 |
| Conjugate | Unconjugated |
| Form | Liquid |
| Purification Method | Antigen affinity purification |
| UNIPROT ID | P32929 |
| Storage Buffer | PBS with 0.02% sodium azide and 50% glycerol, pH 7.3. |
| Storage Conditions | Store at -20°C. Stable for one year after shipment. Aliquoting is unnecessary for -20oC storage. 20ul sizes contain 0.1% BSA. |
Background Information
CTH, also named as Gamma-cystathionase and CSE, belongs to the transsulfuration enzymes family. It catalyzes the last step in the transsulfuration pathway from methionine to cysteine. CTH converts two cysteine molecules to lanthionine and hydrogen sulfide. CTH can also accept homocysteine as substrate. It specificity depends on the levels of the endogenous substrates. CTH is the major H2S-producing enzyme in kidney, liver, vascular smooth muscle cells and enterocytes. The endogenous production of H2S plays a significant role in the regulation of cellular functions, including cell growth, hyperpolarization of cell membranes, modulation of neuronal excitability and relaxation of smooth muscle cells. The CSE/H2S pathway is upregulated in the heart in a murine model of CVB3-induced myocarditis and that inhibition of endogenous H2S is beneficial to treatment early in the disease while administration of exogenous H2S is protective to infected myocardium during the later stage. Mutations in the gene encoding CTH can result in the autosomal recessive disease cystathioninuria; a disorder characterized by the unusual accumulation of plasma cystathionine causing increased urinary excretion. Both male and female CTH-null mice showed hypercystathioninemia and hyperhomocysteinemia, but not hypermethioninemia. CSE has also been reported to be expressed in endothelial cells and contribute to endothelium-dependent vasorelaxation. It can be detected a minor 36 kDa band probably representing a degradative intermediate except the major 43 kDa band in vitamin B6-deficient rat liver(PMID:8660672). CTH also can be detected as ~70kD in rat liver (PMID: 18974309). This antibody is a rabbit polyclonal antibody raised against residues near the C terminus of human CTH.
Protocols
| Product Specific Protocols | |
|---|---|
| FC protocol for Gamma Cystathionase antibody 12217-1-AP | Download protocol |
| IF protocol for Gamma Cystathionase antibody 12217-1-AP | Download protocol |
| IHC protocol for Gamma Cystathionase antibody 12217-1-AP | Download protocol |
| IP protocol for Gamma Cystathionase antibody 12217-1-AP | Download protocol |
| WB protocol for Gamma Cystathionase antibody 12217-1-AP | Download protocol |
| Standard Protocols | |
|---|---|
| Click here to view our Standard Protocols |
Publications
| Species | Application | Title |
|---|---|---|
Cell Metab Transsulfuration Activity Can Support Cell Growth upon Extracellular Cysteine Limitation. | ||
Cell Metab Fibroblast Growth Factor 21 Drives Dynamics of Local and Systemic Stress Responses in Mitochondrial Myopathy with mtDNA Deletions. | ||
Cell Metab mTORC1 Regulates Mitochondrial Integrated Stress Response and Mitochondrial Myopathy Progression. | ||
Cell Metab Mitochondrial DNA Replication Defects Disturb Cellular dNTP Pools and Remodel One-Carbon Metabolism. | ||
Mol Cell SREBP-1c impairs ULK1 sulfhydration-mediated autophagic flux to promote hepatic steatosis in high-fat-diet-fed mice.
|
Reviews
The reviews below have been submitted by verified Proteintech customers who received an incentive for providing their feedback.
FH Piruthivi (Verified Customer) (12-09-2019) | Western blot was very clear.
|